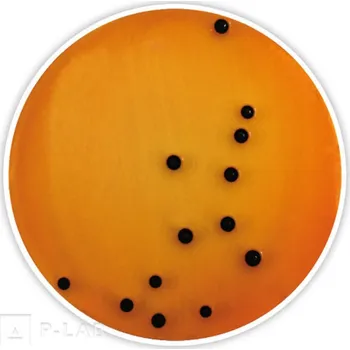
Průmyslové lepidlo Deoxycholát citrátový agar (Specifikace: Ph.Eur., pro mikrobiologii, Balení: 1 kg, Obal: plast)

Udává maximální tahovou sílu, kterou může lepidlo vydržet, aniž by došlo k jeho selhání nebo porušení
Průmyslová lepidla k odběru v Ústeckém kraji
- Podle oblíbenosti
Seznam produktů kategorie

OXID DEUTERIA (Čistota: 99,97 % pro NMR spektroskopii, Obal: sklo, Balení: 50 ml)
Vybavte si snadno, rychle a spolehlivě vaši laboratoř…
P-LAB

3M Jednokrokový základní nátěr pro lepidla, 30 ml
- 30 ml
Lepidlo montážní, zajistí pevný typ spoje, vhodné na Kov a Sklo Klíčové vlastnosti 3M jednokrokového základního nátěru pro…
v 2 obchodech

Liqui Moly Lepidlo LIQUIFAST 1502 400ml (6140)
- 400 ml
Jednokomponentní PU vysokomodulové nevodivé lepidlo pro lepení autoskel za studena s velmi rychlým vytvrzováním. Je určené…
v 8 obchodech

Decoupage lepidlo na textil Nerchau 250 ml (Decoupage lepidlo na textil Nerchau 250…
- 250 ml
Decoupage medium určené speciálně pro aplikaci na textilie se používá jako lepidlo i jako průhledný lak. Umožňuje přenést…
v 3 obchodech

LOCTITE Sada pro lepení zpětného zrcátka 319-0,5g
Obsah [g]: 0.5…
AUTO KELLY

Ráj dřeva Jacer LION GLUE ELASTICKÉ LEPIDLO BÍLÉ 25ml Příslušenství
- 25 ml
LION GLUE ELASTICKÉ LEPIDLO BÍLÉ 25ml Příslušenství…
Ráj dřeva Jacer

Sítko plastové Den Braven CVX – 15×85 mm
Plastové sítko. Použití Pro kotvení svorníků a armovacích výztuh v dutých materiálech Vlastnosti Sítko vložíte do vyvrtaného…
PRO-DOMA

Zhermack ZetaPlus Putty silikonová otiskovací hmota, 900 ml
- 900 ml
Silikonová putty pro otisky s vysokou zatékavostí, stabilní tvrdostí po ztuhnutí a mátovou příchutí. Snadné míchání a…
TOP-DENT

GLYCIN (Specifikace: min 99 %, p.a., PUFFERAN®, Balení: 5 kg)
Vybavte si snadno, rychle a spolehlivě vaši laboratoř…
P-LAB

GLYCIN (Specifikace: min 99 %, pro syntézu, Balení: 10 kg)
Vybavte si snadno, rychle a spolehlivě vaši laboratoř…
P-LAB
Deoxycholát citrátový agar (Specifikace: Ph.Eur., pro mikrobiologii, Balení: 1 kg,…
Vybavte si snadno, rychle a spolehlivě vaši laboratoř…
P-LAB

Würth Chemická injektážní malta WIT-EA 150 ml
- 150 ml
Chemická kotva - pro plné zdivo a beton bez trhlin, teplota zpracování 5 až 40 °C, teplotní odolnost do 50 °C krátkodobě 80…
Alza.cz

BUTTERFLY Lepidlo Free Chack 90 ml
- 90 ml
Lepidlo na stolní tenis Lepidlo BUTTERFLY Free Chack je speciálně navrženo pro lepení potahů pingpongových pálek. Využijete…
Alza.cz

DP8610NS SCOTCH-WELD 3M vysoce flexibilní strukturální lepidlo s prodloužením více…
- 45 ml
SCOTCH-WELD DP8610NS 3M vysoce flexibilní strukturální lepidlo s prodloužením více než 200%, 45 ml Flexibilní akrylové…
v 3 obchodech

Würth Rychleschnoucí nástřikové lepidlo WURTH pro lehké materiály, 500 ml
- 500 ml
Nástřikové lepidlo k lepení všech lehkých materiálů od firmy Würth. Rychleschnoucí kontaktní a montážní lepidlo pro všechny…
v 5 obchodech

LOVELY cream remover Aloe vera 15 g
- 0,02 kg
Odstraňovač lepidla - rychle a šetrně rozpouští lepidlo během 5 - 10 minut, pH 7,5 Dopřejte si bezpečné a šetrné odstranění…
v 2 obchodech

Würth Zimní injektážní malta WIT Nordic 420 ml
- 420 ml
Chemická kotva - pro upevnění dřevěných a kovových konstrukcí, kovové profily, konzole a instalace, teplota zpracování -20…
Alza.cz

LOVELY cream remover Caramel 15 g
- 0,02 kg
Odstraňovač lepidla - rychle a šetrně rozpouští lepidlo během 5 - 10 minut, pH 7,5 Dopřejte si bezpečné a šetrné odstranění…
v 2 obchodech

Liqui Moly Lepidlo LIQUIFAST 1502 310ml (6139)
- 310 ml
Jednokomponentní PU vysokomodulové nevodivé lepidlo pro lepení autoskel za studena s velmi rychlým vytvrzováním. Je určené…
v 12 obchodech

Petec 2-komponent.EPOXY lepidlo 50ml
AC P98050 Dvoukomponentní epoxypryskyřičné lepidlo pro profesionální lepení řady materiálů v praktickém dávkovači dokonale…
Oleje-shop.cz

Petec Lepidlo na polyur.plasty 50ml
AC P98350 Dvoukomponentní lepidlo vysoce vazké na bázi polyuretanu pro profesionální lepení umělých hmot / plastů v…
Oleje-shop.cz

Coyote Silkal 93 5 l
- 5000 ml
Coyote Silkal 93Coyote Silkal 93 je vysoce účinné mazivo určené pro širokou škálu aplikací, včetně ložisek, čepů,…
v 5 obchodech

Lepidlo na fotografie 3M ve spreji 400ml (Lepidlo na fotografie 3M ve spreji 400ml)
- 400 ml
Lepidlo ve spreji od světové značky 3M vhodné především pro lepení fotografií a obrazových materiálů. Lepidlo zajišťuje…
v 9 obchodech

Manetti Mixtion italský, Lepidlo na zlato Vybrat druh: Mixtion 12 hod., Velikost…
Italský Mixtion - spolehlivé lepidlo na olejové báziMixtion italský, je lepící prostředek, který se využívá při…
v 3 obchodech

Průmyslové lepidlo MS 220-60 černá kartuše 290ml
Obsah [ml]: 290 Lepený materiál: dřevo Lepený materiál: kovy Lepený materiál: plasty Konzistence (vlastnost): pasta Chemická…
AUTO KELLY

LOCTITE Metal Magic steel 3463 - 50g
Obsah [g]: 50 Lepený materiál: kovy Konzistence (vlastnost): polotuhý Chemická vlastnost: korozivzdorný Chemická vlastnost:…
AUTO KELLY

Teroson Bond 60 True Primerless (PU 9097 PL HMLC) - 310 ml tmel pro přímé zasklívání
- 310 ml
Pokyny pro montáž, demontáž a čištění naleznete v technickém listu produktu. Bezpečnostní list Teroson Terostat 9097 na…
v 6 obchodech

LOCTITE Oprava vyhřívání zadního skla 3863 - 2g
Obsah [g]: 2 Typ obalu: láhev…
AUTO KELLY

Ráj dřeva Jacer Lepidlo na dřevo Hranicoll D3 - 800 ml, disperzní lepidlo…
- 800 ml
Lepidlo na dřevo Hranicoll D3 - 800 ml, disperzní lepidlo Příslušenství…
Ráj dřeva Jacer

Ráj dřeva Jacer Lepidlo na dřevo Hranicoll D4 - 800 ml, disperzní lepidlo…
- 800 ml
Lepidlo na dřevo Hranicoll D4 - 800 ml, disperzní lepidlo Příslušenství - Spojovací materiál…
Ráj dřeva Jacer

Ráj dřeva Jacer Univerzální lepidlo CZ LION GLUE ELASTICKÉ LEPIDLO BÍLÉ 290ml…
- 290 ml
Univerzální lepidlo CZ LION GLUE ELASTICKÉ LEPIDLO BÍLÉ 290ml Příslušenství…
Ráj dřeva Jacer

Ráj dřeva Jacer Lepidlo na dřevo Hranifix - kontaktní lep. PREMIUM 500 ml, aerosol…
- 500 ml
Lepidlo na dřevo Hranifix - kontaktní lep. PREMIUM 500 ml, aerosol Příslušenství…
Ráj dřeva Jacer

Den Braven Náhradní aplikační špičky pro chemické kotvy 3 ks
- 0,2 kg
Pro opakované použití chemických kotev. Při zatvrdnutí obou složek v aplikační trysce ji lehce nahradíte novou – náhradní.…
v 3 obchodech

Lepidlo univerzální kontaktní Soudal – 50 ml
- 50 ml
Všestranně použitelné kontaktní lepidlo určené pro lepení savých i nesavých materiálů. Vyznačuje se vysokou pevností spoje,…
PRO-DOMA

Špička náhradní na tekutou kotvu blistr – 3 ks
Pro opakované použití Chemických kotev. Při zatvrdnutí obou složek v aplikační trysce ji lehce nahradíte novou – náhradní.…
PRO-DOMA

Lepidlo Pattex Repair Epoxy Uni – 6 ml
- 6 ml
Vlastnosti: Univerzální využití Odolné proti vodě, oleji a běžným rozpouštědlům Při vytvrzování se nesmršťuje ani nerozpíná…
PRO-DOMA

Lepidlo na polystyren Den Braven RL – 280 ml
- 280 ml
Jednosložkové lepidlo na bázi disperze, vytvrzující odpařením vody, vytváří trvale pevný, vlhkotěsný spoj. Použití Lepení…
PRO-DOMA

Lepidlo na obklady Den Braven – 310 ml
- 310 ml
Pro lepení keramických obkladů a mozaiky, lepení polystyrenových podhledů a ukončovacích lišt, včetně ozdobných dekorů,…
PRO-DOMA

Lepidlo univerzální Bison Strong&Safe – 7ml/g
- 0,01 kg
- 7 ml
Univerzální lepidlo třetího tisíciletí. Pro téměř všechny pružné, pevné, porézní i neporézní materiály. Velmi pevné, rychlé…
PRO-DOMA

VOCO V-Posil Putty Fast A-silikonová hmota na otisky, 2x450ml
- 450 ml
Hydrofilní A-silikon pro přesné otisky s vysokou pevností a rychlou elasticitou po vyjmutí. Krátká intraorální doba tuhnutí,…
TOP-DENT

Vteřinové lepidlo GPX, EXTRA Super řídké
- 0,02 kg
Kyanoakrylát pro rychlé a pevné spoje, lepidlo s maximální možnou viskozitou pro lepení dílů z 3D tiskárny…
Sharplayers e-shop

Aktivátor na vteřinové lepidlo
Aktivátor pro kyanoakrylátová lepidla, urychlovač tvrdnutí vteřiňáku…
Sharplayers e-shop

HYDROGENFOSFOREČNAN SODNÝ DIHYDRÁT (Specifikace: min 99,5 %, p.a., Balení: 10 kg)
Vybavte si snadno, rychle a spolehlivě vaši laboratoř…
P-LAB

GLYCIN (Specifikace: min 99 %, pro biochemii, Balení: 10 kg)
Vybavte si snadno, rychle a spolehlivě vaši laboratoř…
P-LAB

PROTEINÁZA K lyofilizovaná (Aktivita: 30 mAnson U/mg , Teplota skladování: + 4 °C,…
Nespecifická proteáza se silnou proteolytickou aktivitou pro degradaci proteinů Vhodné pro široké spektrum aplikací v…
P-LAB

PROTEINÁZA K lyofilizovaná (Aktivita: ≥30 U/mg, Teplota skladování: -20 °C, Balení:…
Nespecifická proteáza se silnou proteolytickou aktivitou pro degradaci proteinů Vhodné pro široké spektrum aplikací v…
P-LAB


